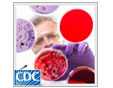

Video and Audio Tools
Listen to and watch the products on this page to learn about the role we all play in using antibiotics wisely and preventing antibiotic resistance.
Podcasts
The following podcasts provide information on how antibiotics work, steps you can take to prevent antibiotic resistance, and tips for using over-the-counter products to help feel better while a viral illness runs its course.

The Story of Peggy Lillis: The Other Side of Antibiotics
Target Audience: General public
View this video on YouTube (2:39 minutes)
In this video, Christian Lillis, son of Peggy Lillis, shares his personal story of losing his mother to a Clostridium difficile infection (C. difficile) caused by antibiotic use.
Date released: November 17, 2016
Antibiotics: Pharmacists Can Make the Difference
Target Audience: General public, particularly parents of young children
Listen to this podcast (2:18 minutes)
In this podcast, a pharmacist counsels a frustrated father about appropriate antibiotic use and symptomatic relief options for his son's cold.
Date Released: 4/16/2015
Antibiotics: Miracle Drugs
Target Audience: General public
Listen to this podcast (2:18 minutes)
The overuse of antibiotics has led to the development of resistance among bacteria, making antibiotics ineffective in treating certain conditions. This podcast discusses the importance of talking to your healthcare professional about whether or not antibiotics will be beneficial if you’ve been diagnosed with an infectious disease.
Date Released: 4/16/2015
Know When Antibiotics Work
Target Audience: General public, particularly parents of young children
Listen to this podcast (1:12 minutes)
This podcast provides a brief background about antibiotics and quick tips to help prevent antibiotic resistance.
Date Released: 4/16/2015
Radio Public Service Announcements
The following radio public service announcements (PSAs) are available to use with CDC’s contact information or can be adapted to include local contact information.

Warning: Get Smart
Target Audience: Healthy adults ages 18–49 years
- Listen to this PSA on Windows Media (0.30 minutes) (Read PSA text)
If you get sick with a cold or the flu this season, ask your healthcare provider what’s best. Learn what you can do to relieve your symptoms and get well.
Date Released: 9/17/2003
Television Public Service Announcements
The following television PSAs are available to use with CDC’s contact information or can be adapted to include local contact information.

Parents Want To Do What's Best
Target Audience: Parents of young children
View this PSA on CDC-TV or on YouTube (0:30 minutes)
Download NTSC Broadcast Quality Video (110 MB)
When your child is sick, antibiotics may not be the answer. Work with your child’s doctor or nurse to learn how you can help your child feel better.
Date Released: 10/25/2012
Videos for Healthcare Professionals
The following videos discuss the important role of judicious antibiotic prescribing in providing high-quality care.
Bob Video
Target Audience: Clinicians
View this video from the Global Respiratory Infection Partnership (2:15 minutes)
Date Released: 8/18/2014
CDC Commentary: Antibiotic Stewardship in the Outpatient Setting
Target Audience: Clinicians
View this video on Medscape (5:54 minutes)
Overview of CDC’s latest resource to support antibiotic stewardship in the outpatient setting: the Core Elements of Outpatient Antibiotic Stewardship.
Date Released: 11/14/2016
CDC Commentary: Antibiotics for Acute Otitis Media in Children
Target Audience: Pediatricians and clinicians who care for children
View this video on Medscape (5:35 minutes)
Principles of judicious antibiotic prescribing related to AAP’s clinical practice guidelines for the diagnosis and management of acute otitis media.
Date Released: 11/19/2013
CDC Commentary: Don’t Give In and Give Those Antibiotics!
Target Audience: Clinicians
View this video on Medscape (3:45 minutes)
Tips on how to communicate with patients about appropriate antibiotic prescribing for upper respiratory infections.
Date Released: 11/8/2010
Videos for Patients and Parents
How Antibiotic Resistance Happens
View this video (0:23 minutes) or on YouTube (0.23 minutes)
This short video briefly explains what causes antibiotic resistance to occur.
Date Released: 7/14/2016
Learn more about appropriate antibiotic prescribing and how to feel better when you have a sore throat, ear or sinus pain, fever, cough or runny nose.
Snort. Sniffle. Sneeze. No Antibiotics Please!
Target Audience: Parents of young children
View this video on CDC-TV or on YouTube (3:47 minutes)
The video features a doctor, who's also a concerned mom, and a humorous turn on a possible doctor's visit.
Date Released: 9/2/2009
Related Pages
- Podcast: Prescribing Antibiotics in the Outpatient Setting (CIDRAP) (21:36 minutes)
- Podcast: Methicillin-resistant Staphylococcus aureus (MRSA) (4:57 minutes)
- Spanish Podcast: Staphylococcus aureus resistente a la meticilina (SARM) (6:09 minutes)
- Podcast: All You Have to Do is Wash Your Hands (3:10 minutes)
- Spanish Podcast: La higiene de las manos salva vidas: Video para el ingreso de pacientes (5:31 minutes)
- Podcast: Put Your Hands Together (3:48 minutes)
- Video: Put Your Hands Together on CDC-TV or on YouTube
- Page last reviewed: December 21, 2016
- Page last updated: February 9, 2017
- Content source:
ShareCompartir